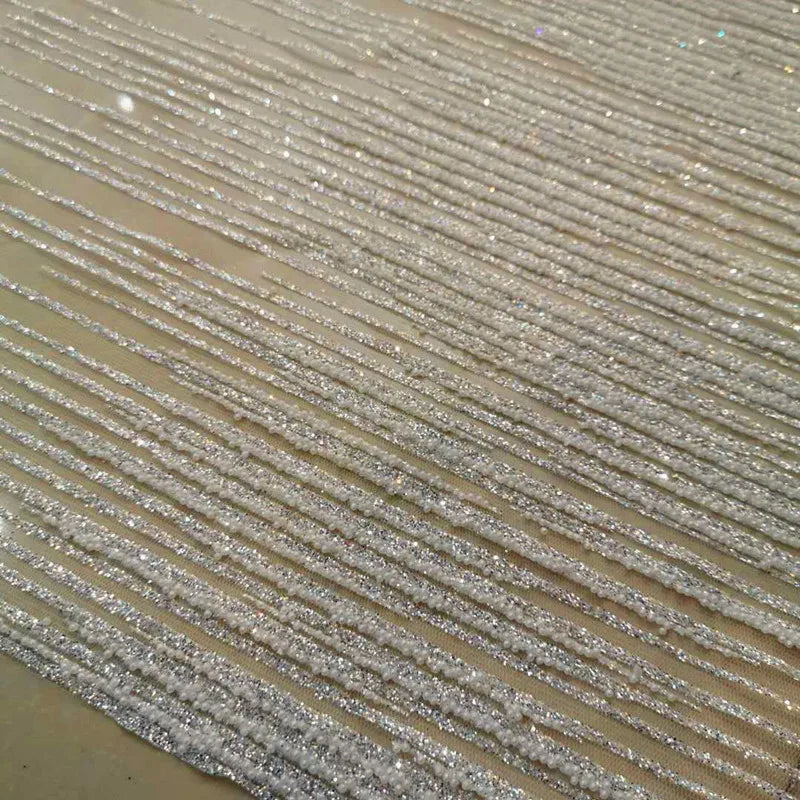
Customized White Small Pearl Hot Stamping Gold And Silver Color Diamond Mesh Wedding Dress Fashion Designer Lace Soft Fabric

-
نقاط بولكا لامعة، ختم ذهبي ساخن، قماش شبكي لامع، فستان رسمي، بدلة أداء، ديكور خلفية، قماش -
Customized White Small Pearl Hot Stamping Gold And Silver Color Diamond Mesh Wedding Dress Fashion Designer Lace Soft Fabric -
ختم ساخن نمط النيزك الإبداعي شفاف غزل صلب DIY فستان سهرة تصميم ديكور مادة نسيج غزل صلب